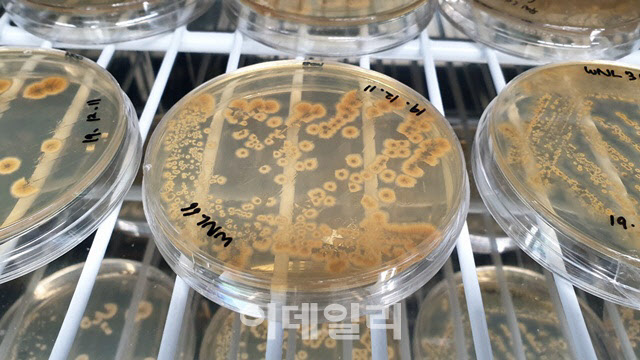

우주생물학 분야 중에서도 ‘미생물’은 우주인의 몸속 변화를 파악하고, 극한의 우주 환경에서 견디는 데 활용할 수 있다는 점에서 관심을 받고 있습니다. 지구나 국제우주정거장(ISS), 우주선에서 연구개발이 이뤄지고 있고, 관련 연구들이 신약개발 같은 성과로도 이어지고 있습니다.
|
인류와도 밀접한 연관이 있습니다. 우리 몸속에는 100조개 이상의 미생물이 활동하고 있습니다. 무게만 1.5kg~2kg 수준입니다. 어떤 이들은 몸 세포보다 미생물 종류가 많다고 하거나, 세포 갯수로 말하면 인간은 미생물 덩어리라고도 표현합니다. 그만큼 미생물이 많고, 우리 몸에 영향을 끼친다는 얘기입니다.
미생물은 주로 눈부터 소장, 대장, 맹장, 성기 등 몸 전체에 포진돼 있습니다. 미생물은 식품 섭취, 생리활동에 따라 비율이 증감합니다. 좋은 미생물과 나쁜 미생물이 공존하며 우리 몸의 항상성을 유지하려 합니다. 이 비율에 따라 체질에 변화가 발생하기도 합니다. 최근에는 미생물의 대사활동이 뇌 대사활동과도 연관돼 정신 건강에 영향을 준다는 뇌장축(Gut-Brain-Axis) 연구결과도 있습니다.
이러한 점에서 미생물은 우주 탐사에 앞서 연구가 필요한 분야입니다. 인류가 달이나 화성까지 가기 위한 로켓이나 장비개발도 중요하지만, 우주선에서 우주인들이 생리활동, 식사 같은 활동에서도 몸의 균형을 유지해야 합니다. 미래에 인류 우주기지가 건설되려면 각종 조건들도 상세히 파악해야 합니다.
그렇다면 미생물 연구는 어떻게 이뤄져 왔을까요? 과학자들은 땅, 바다, 음식 등에서 미생물을 분리해서 하나만 뽑아서 이를 증식합니다. 어떠한 미생물인지 이름을 짓고, DNA를 추출해 컴퓨터로 DNA 염기서열을 분석합니다. 그 결과를 기존 연구 자료와 비교해 특성을 분석합니다.
우주에 생명체가 존재하려면 극한의 온도와 우주에서 날아오는 고에너지의 우주선을 견뎌야 합니다. 이에 과학자들은 지구에서 극한의 환경을 견디는 미생물을 찾거나 우주로 이를 보내 실험하고, 우주 공간에서 물질을 합성하는 연구도 진행하고 있습니다.
방사능 물질에서도 생육할 수 있는 미생물인 데이노코커스 라디오두란스(deinococcus radiodurans)가 대표적입니다. 이 미생물을 극한의 환경에서 노출시켜 생존 여부를 파악하고, 진공상태의 우주공간에서 실험해 특성을 파악할 수 있습니다.
DNA를 조작해서 인공적으로 세포를 만드는 합성생물학도 발전하는 추세입니다. 인류는 극저온 전자현미경(크라이오 EM)을 이용해 미세한 분자까지 연구했지만, 관찰 영역에 한계가 있습니다.
우주에서는 압력, 온도, 진공 등 극한의 조건에서 실험할 수 있어 생체 정보를 정밀히 파악하고, 단백질 구조 분석 등을 통해 신약 개발에도 활용할 수 있습니다. 최근에는 우주환경에서 인공세포를 합성하기 위한 공정에 로봇도 활용되고 있습니다.
정흥채 한국생명공학연구원 박사는 “극한의 환경을 견디는 미생물은 인류가 우주에서 거주하기 위한 구조적·생리적 특성을 파악하는 연구에 활용할 수 있다”며 “인류 우주 탐사 시대가 오는 가운데 우주 연구와 생명 연구를 융합한 연구의 중요성이 커지고, 우주에서 우리 몸속 변화를 파악하는 것도 중요해질 것”이라고 말했습니다.
*이번 편은 정흥채 한국생명공학연구원 박사의 도움을 받았습니다.
*편집자주:우주 시대가 눈앞에 다가오고 있다. 우주는 먼 미래가 아닌 현실이다. 스페이스X, 블루오리진 등 민간기업들의 경쟁과 각종 우주기술 발전으로 민간우주여행시대가 열리고 있다. 관광뿐 아니라 우주 쓰레기 처리, 장례식장, 별똥별 이벤트 등 우주를 상업적으로 이용하려는 시도들도 이어지고 있다. 외계행성에서 생명체를 찾는 인류의 노력도 계속 진화 중이다. 우주는 첨단 과학기술의 집합체이기도 하다. 극한 환경의 우주에 최적화된 첨단 우주 기술들은 필수다. 세계 각국은 광활한 우주시장 선점을 위해 열띤 각축을 벌이고 있다. 국내외 우주 전문가들의 도움을 받아 우주 관련 기술, 우주의 역사, 연구 동향을 소개한다. 이를 통해 우주 개발의 필요성을 환기하고 우주에 대한 관심과 흥미를 유발하고자 한다.

!["고맙다"...'제자와 부적절 관계' 들통난 교사가 남편에 한 말 [그해 오늘]](https://image.edaily.co.kr/images/vision/files/NP/S/2025/12/PS25121500001t.jpg)


